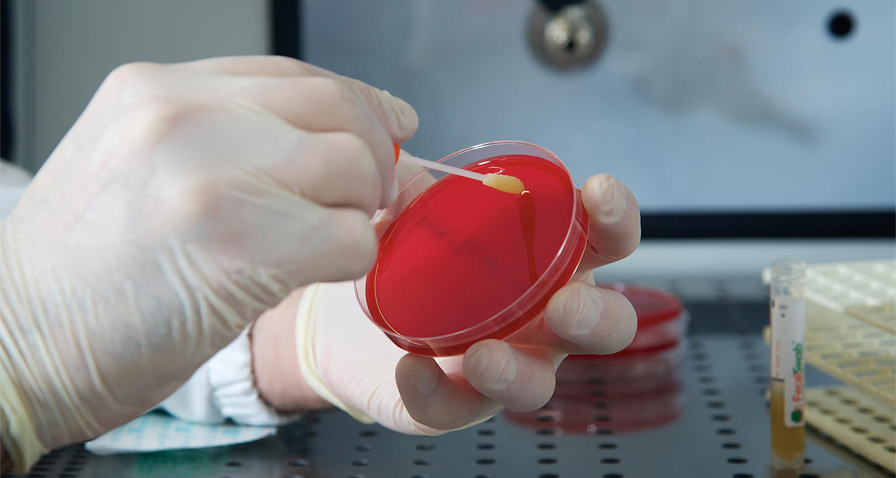

A lo largo de los años, desde BD hemos mejorado una amplia gama de nuestras especialidades farmacéuticas para ayudar a los clientes a aislar y diferenciar los microorganismos patógenos de los no patógenos de manera más efectiva. Las formulaciones de medios cromogénicos están entre las últimas mejoras que hemos desarrollado y lanzado al mercado.
La disponibilidad local y el envío garantizan que cuando los medios preparados BD BBL™ lleguen a su laboratorio, esten listos para usarse de manera correcta (si se almacenan y usan como se indica en el inserto). Todos los medios de cultivo cumplen con los estándares del CLSI (Instituto de Estándares Clínicos y de Laboratorio), según corresponda.